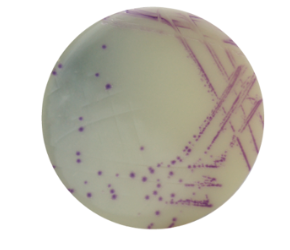
国标GB 4789.9—2014空肠弯曲菌检验程序

9 年
手机商铺
公司新闻/正文
335 人阅读发布时间:2018-10-29 13:56
空肠弯曲菌 ( Campylobacter jejuni) 是一种人畜共患病病原菌,可以引起动物和人发生多种疾病。该菌广泛存在于鸟、禽、狗、猫等动物体内,可通过污染肉、奶及未经消毒处理的水而导致感染,其涉及到的食品有生的和未煮熟的鸡、生的和巴氏杀菌不彻底的牛奶、蛋制品、生火腿等。
空肠弯曲菌是一种革兰氏阴性微需氧菌,在中性 pH 值、42℃ 条件下生长良好,对温度、营养、pH 值、水等条件要求苛刻,在外界环境压力下容易进入活的非可培养状态。目前,包括我国在内的许多国家对空肠弯曲菌的检验普遍采用传统培养方法。在我国现行的空肠弯曲菌的检验的标准方法是《食品安全国家标准 食品微生物学检验 空肠弯曲菌检验》GB 4789.9—2014,具体检测程序如下:

根据国标GB 4789.9—2014预增菌与增菌后,划线分离菌种,接种于mCCDA平板,另外缔一生物推荐您使用HiMedia公司(国际知名微生物公司)弯曲菌显色培养基(货号:M2020)进行分离。
传统的弯曲菌培养基,是使用改良的黑色活性炭头孢哌酮脱氧胆酸琼脂(mCCDA)。但弯曲菌菌落在黑色的培养基上为无色,通常很难检测到。因此HiMedia公司弯曲菌显色培养基在mCCDA培养基基础上研发出来,其鉴别能力远远高于mCCDA培养基。
弯曲菌显色培养基(货号:M2020) 可支持弯曲杆菌的丰饶生长,在此培养基中呈现浅紫至紫色的菌落。
培养基中氯化钠维持渗透压。蛋白胨混合物提供碳源、氮源化合物、长链氨基酸、维生素和其他必需的生长因子。蔗糖是可发酵的碳水化合物。抗生素——弯曲杆菌选择性添加剂(FD178)减少正常肠道菌群的生长,同时增强粪便标本中空肠弯曲菌的生长和恢复。
缔一生物2014年将HiMedia公司引入中国,作为中国地区的总代理,专注于食品安全、微生物培养检测、细胞培养和工业发酵等领域,为国内生产、科研用户提供原装进口的系列产品:微生物培养基和检测试剂、细胞培养用牛血清、支原体检测和祛除试剂、qPCR仪、自动核酸提取仪等。